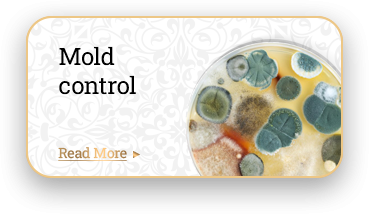

*एक रनिंग मीटर सामान्य एक मीटर की लंबाई के बराबर होता है।
| लंबाई | कीमत, AED |
|---|---|
| 100 मीटर तक | 40 प्रति मीटर |
| 100 से 250 मीटर | 35 प्रति मीटर |
| 250 मीटर से अधिक | 30 प्रति मीटर |
*एक रनिंग मीटर सामान्य एक मीटर की लंबाई के बराबर होता है।
इसके अलावा, हम विभिन्न प्रकार के व्यवसायों के लिए पेशेवर पेस्ट कंट्रोल सेवाएँ भी प्रदान करते हैं:
एक बार की कमर्शियल सर्विस की कीमतें नीचे दी गई हैं। यदि आपको वार्षिक पेस्ट कंट्रोल कॉन्ट्रैक्ट चाहिए, तो कृपया वेबसाइट पर इंक्वायरी फ़ॉर्म भरें या हमें कॉल करें।
1) रिक्वेस्ट फॉर्म भरने के बाद हमारे मैनेजर आपको विवरण स्पष्ट करने के लिए संपर्क करेंगे;
2) हमारे विशेषज्ञ तय समय पर ठीक-ठीक पहुँचते हैं;
3) पहला कदम साइट/ऑब्जेक्ट का निरीक्षण करना है;
4) फिर हम आपके साथ सेवा अनुबंध पर हस्ताक्षर करते हैं;
5) इसके बाद हमारे विशेषज्ञ प्रोसेसिंग शुरू करते हैं;
6) पूरी प्रक्रिया अधिकतम 40 मिनट लेती है।
हमारी कंपनी पक्षी नियंत्रण सेवाएँ प्रदान करती है। यह सेवा मानव गतिविधि के कई क्षेत्रों में मांग में है—घर के बगीचे/प्लॉट से लेकर फूड इंडस्ट्री और ट्रेड तक।
कई पक्षी पर्यावरण के अनुरूप तेजी से ढल जाते हैं और लोगों के पास कॉलोनियों में बस जाते हैं। इससे उनकी “समझ” भी प्रभावित होती है: वे संभावित खतरे को पहचान सकते हैं, जाल में नहीं फँसते, जिन लोगों से उन्हें खतरा महसूस होता है उन्हें याद रखते हैं और उनसे हर संभव तरीके से बचते हैं। इसलिए पक्षियों से छुटकारा, उन्हें हटाना या उनकी संख्या पर नियंत्रण—इन सबके लिए व्यवस्थित तरीका और अलग-अलग टूल्स की जरूरत पड़ सकती है।
पक्षी मानव जीवन के कई पहलुओं में बड़ा नुकसान पहुँचा सकते हैं:
– पक्षियों की बीट की रासायनिक संरचना कार या किसी इंजीनियरिंग संरचना की पेंट सतह को खराब कर सकती है;
– पक्षी वेयरहाउस, अनाज भंडार और सुपरमार्केट में खाद्य/सामान के स्टॉक को नष्ट करते हैं, पैकेजिंग की सील तोड़ते हैं, बीट और पंखों से उत्पादों को दूषित करते हैं, और अपने साथ कीट-परजीवी भी लाते हैं;
– पक्षी कई खतरनाक बीमारियों के वाहक होते हैं: क्लैमाइडिया, हेपेटाइटिस, ट्यूबरकुलोसिस, बर्ड फ्लू, साल्मोनेलोसिस आदि। कार्य-क्षेत्र में उनकी मौजूदगी से स्वच्छता की स्थिति पर नकारात्मक असर पड़ता है।
अन्य कीटों के विपरीत, पक्षी नियंत्रण में आम तौर पर उन्हें मारना शामिल नहीं होता। पक्षी नियंत्रण के तरीके मुख्य रूप से संरक्षित स्थानों से पक्षियों को दूर रखने (डराने/हटाने) पर आधारित होते हैं। इसके लिए पक्षियों की जीवविज्ञान और व्यवहार की समझ, और उनके लिए “असुविधाजनक” परिस्थितियाँ बनाना जरूरी होता है। इसके लिए अलग-अलग तकनीकी उपाय अपनाए जाते हैं। कभी-कभी एकमात्र तरीका यह होता है कि पक्षियों के प्रवेश की संभावना ही खत्म कर दी जाए—संभावित एंट्री पॉइंट्स को सावधानी से ब्लॉक करना, सुरक्षा जाल (नेट), ग्रिल/जाली, परदे और कुछ मामलों में व्यक्तिगत पक्षियों के लिए ट्रैप लगाना।
पक्षियों से निपटते समय स्वच्छता और हाइजीन मानकों का पालन करना, और नियमित रोकथाम के उपाय करना बहुत जरूरी है—जिसे अक्सर नज़रअंदाज़ कर दिया जाता है। पक्षियों से निपटना तब आसान होता है जब उन्हें उस जगह पर रहने की मजबूत वजह न मिले। इसलिए साइट की समग्र स्वच्छता पर ध्यान दें—खुले में ऐसे उत्पाद/भोजन न रखें जो पक्षियों के लिए भोजन बन सकते हैं, फूड वेस्ट आदि को भी खुले में न छोड़ें।
– अब तक ठीक-ठीक यह ज्ञात नहीं है कि पक्षियों की उत्पत्ति किन जीवों से हुई। सबसे लोकप्रिय सिद्धांतों में से एक के अनुसार वे डायनासोर से विकसित हुए;
– आज तक पृथ्वी पर रहने वाले पक्षियों की 10,694 प्रजातियाँ ज्ञात हैं;
– पक्षियों को पसीना नहीं आता;
– दुनिया में सबसे आम पक्षी मुर्गियाँ हैं;
– पक्षियों की स्वाद-इंद्रिय अपेक्षाकृत कमजोर होती है;
– गौरैया को सबसे “स्मार्ट” पक्षी माना जाता है, क्योंकि 100 ग्राम वजन पर उसके मस्तिष्क का वजन लगभग 4.5 ग्राम होता है;
– सीगल (समुद्री पक्षी) बिना समस्या के खारा पानी पी सकते हैं, क्योंकि उनकी ग्रंथियाँ नमक को फ़िल्टर करती हैं;
– मुर्गियाँ अपनी जान बचाने के लिए “मरी हुई” होने का नाटक कर सकती हैं;
– आम तौर पर पक्षियों के पंख (फेदर कवर) उनके कंकाल से भारी होते हैं। पेंगुइन या शुतुरमुर्ग जैसे अपवाद जरूर हैं, लेकिन सामान्यतः पंख खोखली हल्की हड्डियों से ज्यादा भारी होते हैं;
– मुर्गे के पास “इन-बिल्ट” ईयर-प्लग होते हैं। जब मुर्गा बाँग देने के लिए मुँह खोलता है, तो उसके कान के रास्ते बंद हो जाते हैं। उसकी आवाज़ 140 डेसिबल तक पहुँच सकती है, इसलिए प्रकृति ने उसे अपनी ही आवाज़ से बहरा होने से बचाने का इंतजाम किया है।